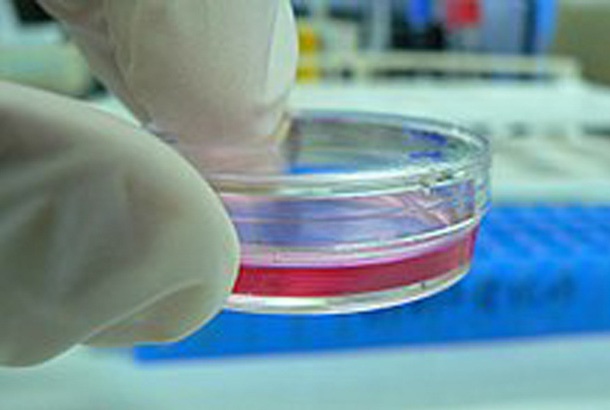
Cell culture

Filtración de sangre animal
La sangre animal Contiene casi todos los nutrientes y elementos que el cuerpo humano necesita, incluidas proteínas, aminoácidos, vitaminas y otros nutrientes, como sodio, potasio, hierro, calcio y otros oligoelementos.
En las técnicas tradicionales, se abandona la mayor parte de la sangre, lo que provoca el desperdicio de recursos, excepcionalmente se utiliza un poco en la producción de piensos. Como una especie de suplemento de hierro vivo, el hemo-hierro, cuya absorción es alta y los efectos secundarios son pequeños pueden ser absorbidos por las células de la membrana mucosa del intestino directamente sin estimular.
Extraer hemo-hierro de la sangre animal tiene un gran valor para el desarrollo. La SOD (superóxido dismutasa) también se extrae de la sangre animal.
Cultivo celular
El cultivo celular es el proceso mediante el cual las células se cultivan en condiciones controladas, generalmente en un equipo de cultivo celular.
Filtración de membrana de cerámicaSe usa con frecuencia en cultivo de células animales para recolección de biorreactores, concentración de proteínas, intercambio de tampón, filtración de virus y filtración estéril. Una variedad de materiales de membrana y tamaños de poro que van desde sueltos
Membranas de microfiltración de cerámicaA membranas de ultrafiltración estrechas, que rechazan proteínas pequeñas, se encuentran con frecuencia en un tren de purificación. Si bien todas estas operaciones utilizan el mismo principio de separación basado en el tamaño, los métodos reales de operación varían significativamente.
La microfiltración es a menudo la primera de las operaciones unitarias en el tren de purificación. Las membranas de microfiltración tienen poros en el rango de tamaño micrómetro. La microfiltración se utiliza para eliminar células y restos celulares. Este capítulo comienza describiendo la microfiltración de flujo tangencial. Se incluye un método típico de operación.
A menudo se requiere la concentración del producto y el intercambio de tampón hacia el final del tren de purificación. Las membranas de ultrafiltración se utilizan para ambas operaciones. La teoría de la ultrafiltración de flujo tangencial se describe brevemente seguida de un método típico de operación.
Hoy en día, las membranas de ultrafiltración de poros grandes (100 de corte de peso molecular-500 kDa) están encontrando aplicaciones cada vez mayores para la filtración de virus. La Validación del limpiador de virus es una preocupación importante en la industria biofarmacéutica. Al mismo tiempo, la purificación de partículas de virus para vacunas virales y aplicaciones en terapia génica es un desafío importante para las separaciones.

Vacuna
Una vacuna es una preparación biológica que proporciona inmunidad adquirida activa a una enfermedad en particular.
Los ingredientes de la vacuna se derivan de una variedad de fuentes que incluyen extractos de tejidos, células bacterianas, partículas de virus, proteínas y ácidos nucleicos recombinantes de mamíferos, levaduras y producidos por células de insectos. El método más común de producción de vacunas se basa en un proceso de fermentación inicial seguido de purificación.

La producción de vacunas es un proceso complejo que implica muchos pasos y procesos diferentes. La selección del método de purificación apropiado es crítica para lograr la pureza deseada del producto final. La aclaración de las vacunas es un paso crítico que afecta fuertemente la recuperación del producto y la posterior purificación posterior.
Hay varias tecnologías que se pueden aplicar para la clarificación de vacunas. La selección de un método y equipo de recolección depende del tipo de células, el producto que se está cosechando y las propiedades de los fluidos del proceso. Estas técnicas incluyen filtración de membrana (microfiltración, filtración de flujo tangencial), centrifugación y filtración en profundidad (filtración de flujo normal). Históricamente, la clarificación de la cosecha de vacunas generalmente se lograba mediante centrifugación seguida de filtración en profundidad.
Recientemente, las tecnologías basadas en membranas han ganado prominencia en la clarificación de vacunas. El uso cada vez mayor de tecnologías de un solo uso en los procesos ascendentes requirió un cambio en las estrategias de cosecha.

Llámanos:
Llámanos:  Envíenos un correo electrónico:
Envíenos un correo electrónico:  N. ° 9 Yuansi Road, Pukou, Nanjing, Jiangsu, China 211808
N. ° 9 Yuansi Road, Pukou, Nanjing, Jiangsu, China 211808